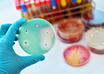

Weight loss may reverse effects of heart rhythm disorder
IANS | Jun 22, 2018
iPad neck pain more common among women than men
IANS | Jun 22, 2018
Human cells are first responders to repair damaged DNAs
ANI | Jun 21, 2018
Living in mountainous regions may affect bone growth: Study
IANS | Jun 21, 2018
Decoded: How toothpaste can contribute to antibiotic resistance
IANS | Jun 21, 2018
'Smart stent' developed to spot narrowing of arteries
IANS | Jun 21, 2018
Plant-based diets can help diabetes patients: Study
IANS | Jun 20, 2018
Excessive drinking in teens may affect short-term memory
IANS | Jun 20, 2018
Grandparents' exposure to plastic chemical can cause autism in kids: Study
IANS | Jun 20, 2018
Most read this week